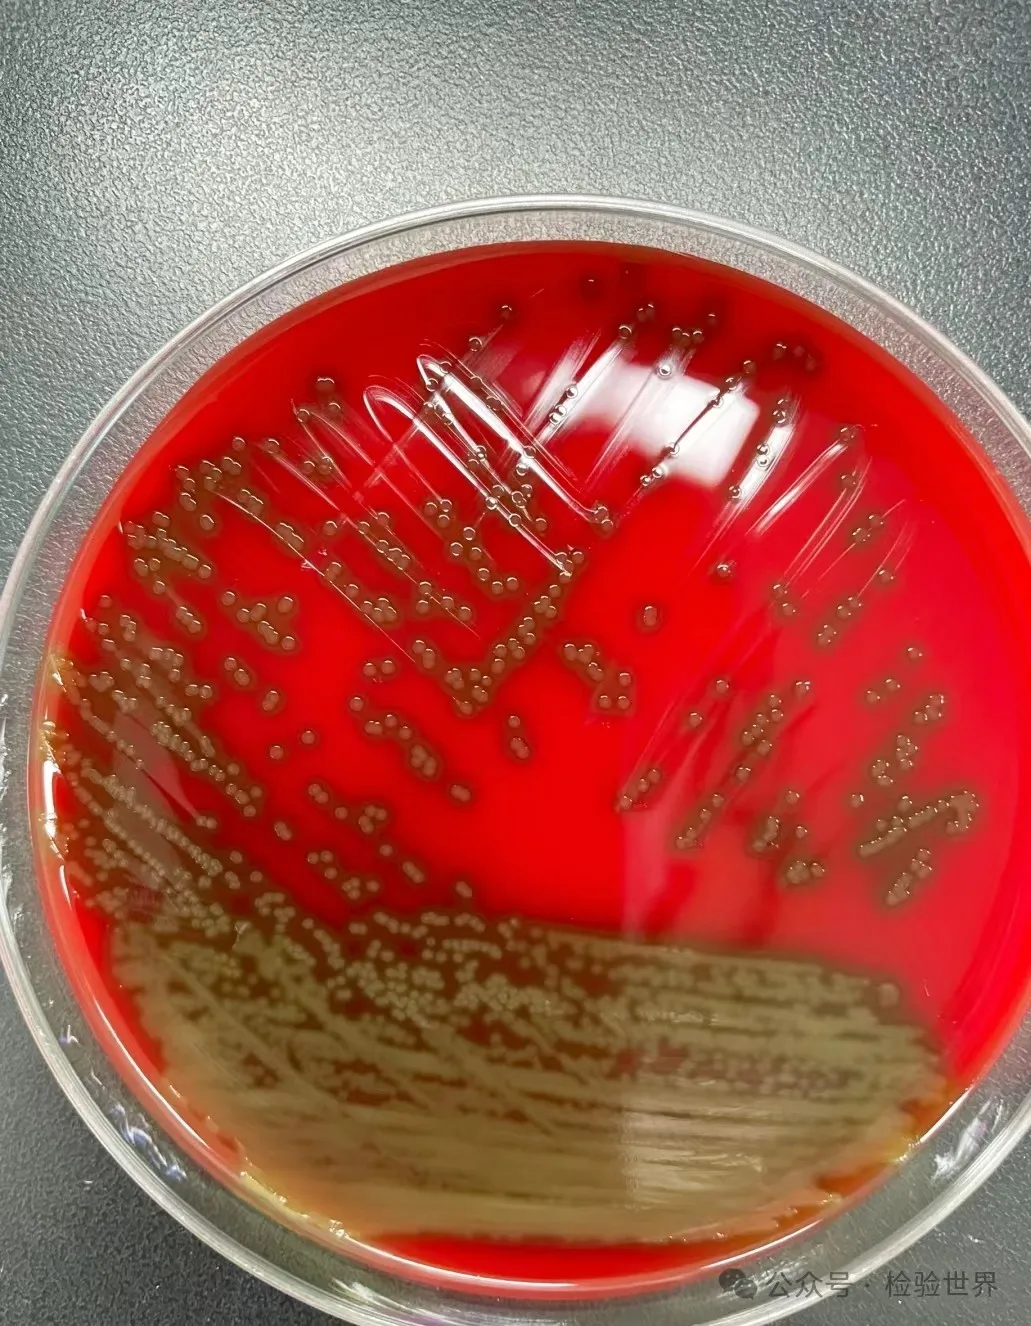
肺炎链球菌培养特性
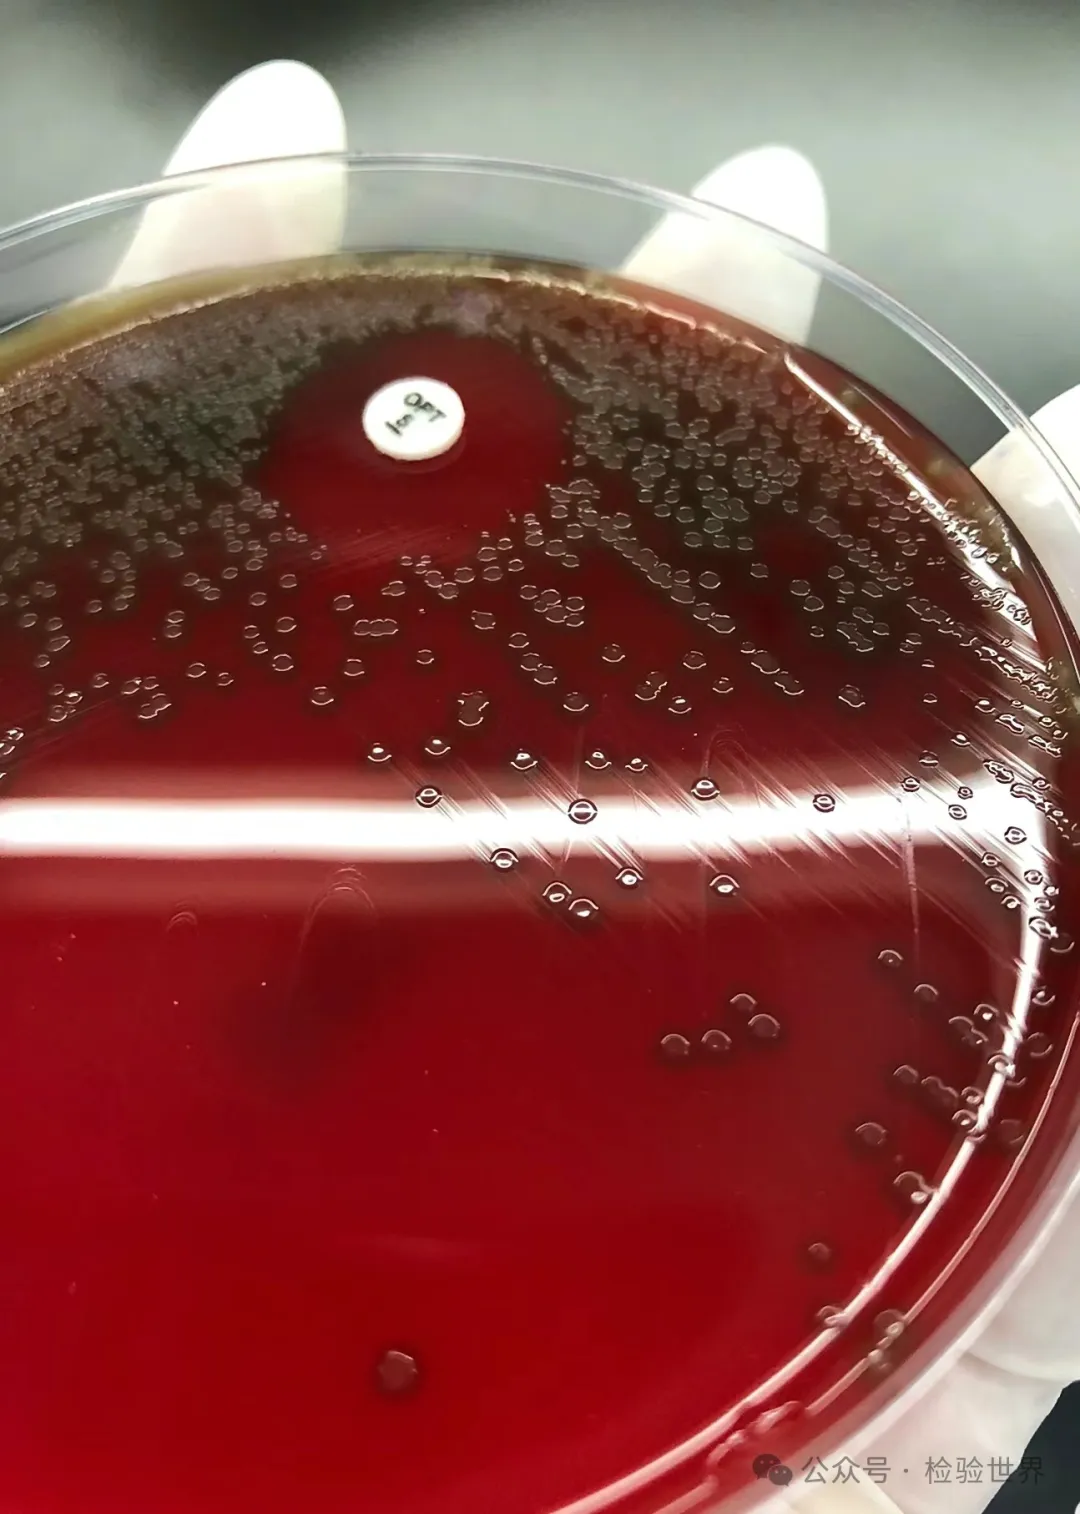
肺炎链球菌生化反应

一篇科普文,带你认识肺炎链球菌
发布时间:2025-01-17 浏览次数:9034
肺炎链球菌是一种属于链球菌科、链球菌属的细菌,旧称肺炎双球菌或肺炎球菌。这种细菌于1881年首次由巴斯德(Louis Pasteur)及G. M. Sternberg分别从患者痰液中分离出。肺炎链球菌的菌体为革兰染色阳性,形状似矛头状,通常成双或成短链状排列。有毒株的菌体外还有一层化学成分为多糖的荚膜。
一、形态与染色
肺炎链球菌(Streptococcus pneumoniae)是一种革兰氏阳性球菌,呈矛头状,常成对或成短链状排列。由于其菌体较小,直径约为0.5~1.5μm,通常需要借助显微镜才能观察其形态。在革兰氏染色法中,该菌呈现为紫色,因此被归类为革兰氏阳性菌。

二、培养特性
肺炎链球菌为需氧或兼性厌氧菌,对营养要求较高。最适生长温度为37℃,最适pH为7.6~7.8。在血琼脂培养基上,肺炎链球菌能产生灰白色、表面光滑、边缘整齐、直径为0.5~1mm的细小菌落,周围有草绿色溶血环。这种溶血环是由肺炎链球菌产生的溶血素引起的,可以破坏红细胞膜,使其中的血红蛋白释放,从而在培养基上形成明显的绿色区域。
三、生化反应
肺炎链球菌能够分解葡萄糖、麦芽糖、乳糖、蔗糖等糖类,产酸但不产气。此外,该菌还能分解尿素和硝酸盐,并在含有血清的培养基中生长良好。这些生化反应有助于在实验室中鉴定肺炎链球菌。
四、抗原结构与分类
肺炎链球菌的荚膜多糖是其主要的抗原成分,根据荚膜多糖的不同,肺炎链球菌可被分为80多个血清型。这些血清型之间的抗原性差异较大,因此不同血清型的肺炎链球菌之间的交叉免疫反应较弱。此外,肺炎链球菌的细胞壁还含有C多糖、M蛋白和脂磷壁酸等抗原成分,这些成分在免疫应答和细菌鉴定中也具有重要意义。
五、致病性与耐药性
肺炎链球菌是一种重要的呼吸道病原菌,能够引起大叶性肺炎、支气管炎、脑膜炎等多种疾病。其致病性主要取决于荚膜多糖和溶血素等毒力因子。此外,随着抗生素的广泛使用,肺炎链球菌的耐药性问题也日益严重。部分肺炎链球菌能够产生β-内酰胺酶,从而水解青霉素等β-内酰胺类抗生素,导致其失去抗菌活性。因此,在临床治疗中需要根据药敏试验结果选择合适的抗生素。
六、致病机制
1、荚膜对组织的侵袭作用:肺炎链球菌的荚膜是由高分子多糖体构成,对肺组织具有侵袭作用, 荚膜的存在使得肺炎链球菌能够抵抗宿主的吞噬作用,从而在宿主组织中大量繁殖。
2、引起肺部炎症反应:肺炎链球菌感染后,首先引起肺泡壁水肿,出现白细胞与红细胞渗出。含菌的渗出液经肺泡间孔向肺的中央部分扩展,甚至累及几个肺段或整个肺叶。这种炎症反应导致肺部出现实变性病变,临床表现为咳嗽、咳痰、高热、胸痛等症状。
3、其他致病因子:除了荚膜外,肺炎链球菌还含有其他致病因子,如肺炎链球菌的表面蛋白A、黏附蛋白A和胆碱结合蛋白等,它们使细菌能够黏附到宿主上。神经氨酸酶可裂解黏膜细胞的唾液酸,使细菌得以定植。自溶素可将细胞壁的磷壁酸和肽聚糖释放出来,激活补体,引起强烈的炎症反应。
4、免疫应答:免疫球蛋白能够特异性地识别肺炎链球菌上的荚膜,并通过FC受体将细菌结合与中性粒细胞表面,使中性粒细胞和吞噬细胞有效地吞噬和杀灭肺炎链球菌。 肺炎链球菌不产生大量的酶,因此其起病往往表现为宿主的炎症反应,很少会导致组织永久性的破坏、坏死等。
5、传播与并发症:肺炎链球菌感染如果不及时治疗,可能进一步引发菌血症、感染性休克、脑膜炎等严重并发症。细菌可能通过血液进入其他部位,引起相应部位的化脓性反应。
在人群中,约5%~10%的正常人上呼吸道中会携带肺炎链球菌,这些细菌主要寄居于人类的上呼吸道,作为正常菌群存在。大部分菌株并不致病或致病力很弱,但部分菌株具有致病力,尤其在机体抵抗力下降时,这些细菌可能会引起疾病。主要的致病因素是细菌荚膜的侵袭作用。

肺炎链球菌能够引起多种疾病,如大叶性肺炎和支气管肺炎。对于成人来说,75%的脑炎是由1、2、3、4、5、7、8、12、14和19等10型的肺炎链球菌引起的,其中半数以上是1、2、3型所致。特别地,3型肺炎链球菌能产生大量荚膜,毒力强,死亡率较高。对于儿童来说,肺炎多由1、6、14和19型引起,其中最常见的是14型。此外,肺炎链球菌感染后还可能继发胸膜炎、脓胸、中耳炎、乳突炎、副鼻窦炎、脑膜炎以及败血症等疾病。

文章来源:环凯(官网:huankai.com)转载于“ 检验世界 ”公众号;原作者~ 星星✨点点。
转载声明:本文为转载发布,仅为分享学习目的。对转载有异议和删稿要求的原著方,可联络站点客服删除。
